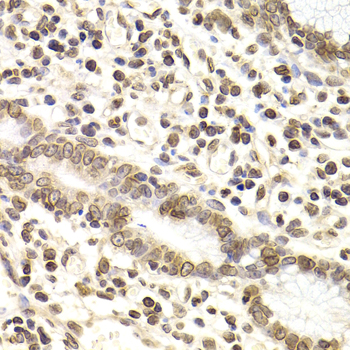
A6483: image 5

For quotations, please use our online quotation form, and you may also contact us by
service@kendallscientific.com
+1-888.733.6849 (Toll-free)
+1-617.299.7367 (Int’l))
+1-888.733.6849
Our customer service representatives are available 24 hours, Monday through Friday to assist you.| Reactivity | Human Mouse Rat |
| Tested applications | WB IHC IF |
| Recommended Dilution | WB 1:500 - 1:2000 IHC 1:50 - 1:200 IF 1:50 - 1:100 |
| Calculated MW | 67kDa |
| Observed MW | Refer to Figures |
| Immunogen | Recombinant protein of human LMNB2 |
| Storage Buffer | Store at -20℃. Avoid freeze / thaw cycles. Buffer: PBS with 0.02% sodium azide, 50% glycerol, pH7.3. |
| Synonym | LMN2; LAMB2; |

Western blot analysis of extracts of various cells, using LMNB2 antibody.

Immunohistochemistry of paraffin-embedded rat brain using LMNB2 antibody at dilution of 1:200 (400x lens).

Immunohistochemistry of paraffin-embedded rat pancreas using LMNB2 antibody at dilution of 1:200 (400x lens).

Immunohistochemistry of paraffin-embedded liver injury using LMNB2 antibody at dilution of 1:200 (400x lens).
Immunohistochemistry of paraffin-embedded human colon cancer using LMNB2 antibody at dilution of 1:200 (400x lens).

Immunohistochemistry of paraffin-embedded human gastric carcinoma using LMNB2 antibody at dilution of 1:200 (400x lens).

Immunohistochemistry of paraffin-embedded mouse brain using LMNB2 antibody at dilution of 1:200 (400x lens).

Immunofluorescence analysis of U2OS cell using LMNB2 antibody. Blue: DAPI for nuclear staining.
This gene encodes a B type nuclear lamin. The nuclear lamina consists of a two-dimensional matrix of proteins located next to the inner nuclear membrane. The lamin family of proteins make up the matrix and are highly conserved in evolution. During mitosis, the lamina matrix is reversibly disassembled as the lamin proteins are phosphorylated. Lamin proteins are thought to be involved in nuclear stability, chromatin structure and gene expression. Vertebrate lamins consist of two types, A and B. Mutations in this gene are associated with acquired partial lipodystrophy.
N/A